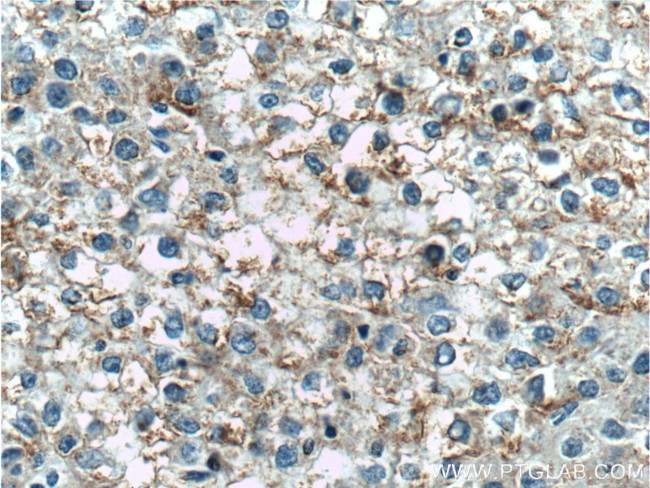
TNFSF8 Antibody in Immunohistochemistry (Paraffin) (IHC (P))

Search
Proteintech
TNFSF8 Polyclonal Antibody
{{$productOrderCtrl.translations['antibody.pdp.commerceCard.promotion.promotions']}}
{{$productOrderCtrl.translations['antibody.pdp.commerceCard.promotion.viewpromo']}}
{{$productOrderCtrl.translations['antibody.pdp.commerceCard.promotion.promocode']}}: {{promo.promoCode}} {{promo.promoTitle}} {{promo.promoDescription}}. {{$productOrderCtrl.translations['antibody.pdp.commerceCard.promotion.learnmore']}}
产品信息
17852-1-AP
种属反应
宿主/亚型
分类
类型
抗原
偶联物
形式
浓度
规格
纯化类型
保存液
内含物
保存条件
运输条件
产品详细信息
Immunogen sequence: VVQRTDSIP NSPDNVPLKG GNCSEDLLCI LKRAPFKKSW AYLQVAKHLN KTKLSWNKDG ILHGVRYQDG NLVIQFPGLY FIICQLQFLV QCPNNSVDLK LELLINKHIK KQALVTVCES GMQTKHVYQN LSQFLLDYLQ VNTTISVNVD TFQYIDTSTF PLENVLSIFL YSNSD (61-234 aa encoded by B C093630)
靶标信息
The ligand for CD30 is CD30L (CD153). The binding of CD30 to CD30L mediates pleiotropic effects including cell proliferation, activation, differentiation, and apoptotic cell death. CD30 has a critical role in the pathophysiology of Hodgkin's disease and other CD30+ lymphomas. CD30 acts as a costimulatory molecule in thymic negative selection. In addition to its expression on Hodgkin's and Reed-Sternberg cells, CD30 is also found in some non-Hodgkin's lymphomas (including Burkitt's lymphomas), virus-infected T and B cells, and on normal T and B cells after activation. In T cells, CD30 expression is present on a subset of T cells that produce Th2-type cytokines and on CD4+/CD8+ thymocytes that coexpress CD45RO and the IL4 receptor.
仅用于科研。不用于诊断过程。未经明确授权不得转售。
篇参考文献 (0)
生物信息学
蛋白别名: CD153; CD153 antigen; CD30 antigen ligand; CD30 ligand; CD30-L; CD30ligand; tumor necrosis factor (ligand) superfamily, member 8; tumor necrosis factor ligand 3A; Tumor necrosis factor ligand superfamily member 8; tumor necrosis factor superfamily member 8; unnamed protein product
基因别名: CD153; CD30L; CD30LG; TNFSF8; TNLG3A
UniProt ID: (Human) P32971, (Mouse) P32972
Entrez Gene ID: (Human) 944, (Mouse) 21949, (Rat) 683163